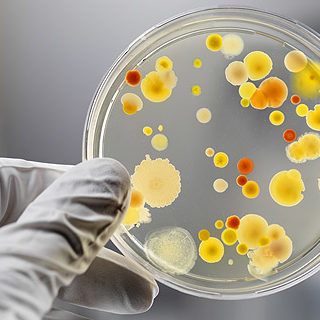
how-to-study-biology

Free Online Courses : Biotechnology and Genetics
Enzyme Science and Engineering Youtube – Subhash Chand, IIT Delhi Biotechnology – biotech and pharmaceutical industry Youtube – Patrick Dixon BioChemistry Youtube – S.Dasgupta, IIT Kharagpur Genetic Engineering and Society Youtube – Bob...